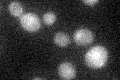
YGL163C
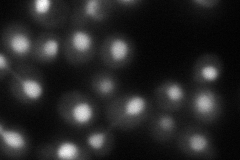
YGL163C
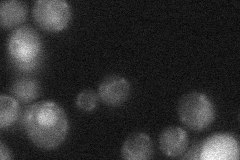
YGL163C

View description
DNA-dependent ATPase, stimulates strand exchange by modifying the topology of double-stranded DNA; involved in the recombinational repair of double-strand breaks in DNA during vegetative growth and meiosis; member of the SWI/SNF family
Localization:
Intensity:
Fold change:
Significance:
-
C’ GFP library in SD
nucleus19.68 -
N' NOP1pr-GFP in SD

nucleus45.3151 -
N' TEF2pr-mCherry in SD
nucleus27.8095 -
N' NATIVEpr-GFP in SD
nucleus21.0901 -
N' TEF2pr-VC and Cyto-VN in SD

below threshold23.3714 -
C’ GFP library in SD+DTT

nucleus17.250.87No -
C’ GFP library in SD+H2O2

nucleus18.890.95No -
C’ GFP library in Starvation Media

nucleus16.530.83No -
C’ GFP library on the background of Pup2-DaMP

nucleus -
C’ GFP library on the background of CCT mutant

nucleus18.91720.960734No
